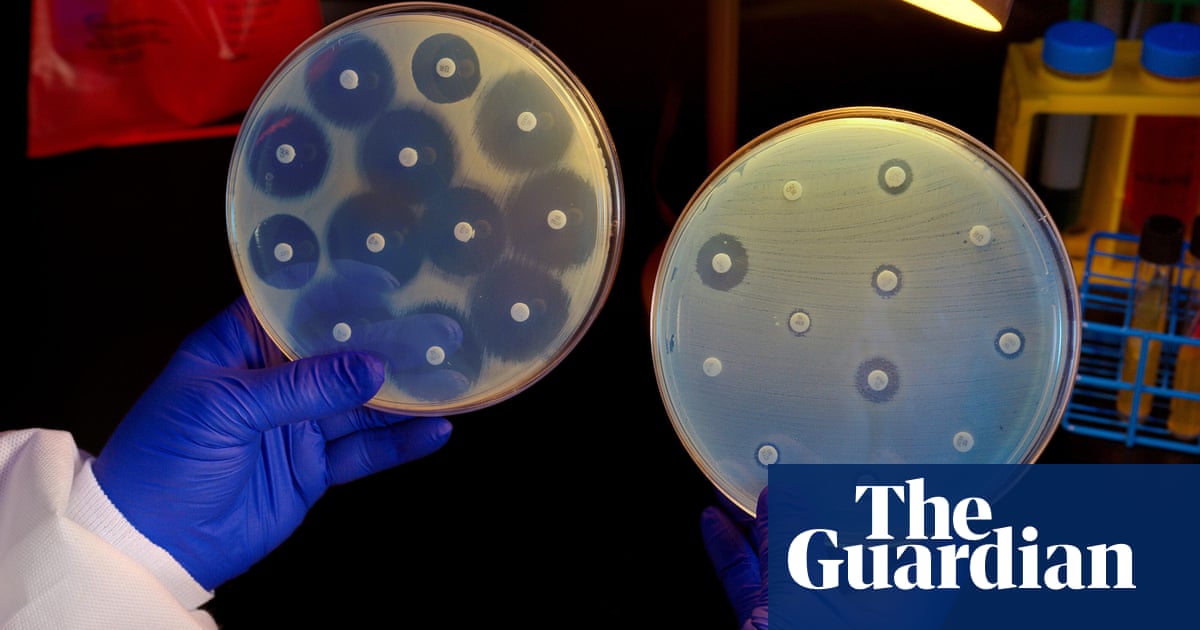

Heartbreaking photo of girl, 5, comforting brother, 4, with leukaemia goes viral
Wed, 09/11/2019 - 01:07
malaysiakini.com - A heartbreaking image showing five-year-old Aubrey Burge comforting her brother Beckett, a year younger, who is suffering from leukaemia, in the washroom, has gone viral, according…
Category: Art & Entertainment
malaysiakini.com - A heartbreaking image showing five-year-old Aubrey Burge comforting her brother Beckett, a year younger, who is suffering from leukaemia, in the washroom, has gone viral, according…

KZN stops hiring ‘foreign doctors’ to accommodate Cuban-trained locals | IOL News
Wed, 09/11/2019 - 00:50
iol.co.za - Durban – The health department in KwaZulu-Natal has put a stop to the hiring of foreign health professionals, particularly doctors, to accommodate Cuban-trained South African doctors. An…
Category: Art & Entertainment
iol.co.za - Durban – The health department in KwaZulu-Natal has put a stop to the hiring of foreign health professionals, particularly doctors, to accommodate Cuban-trained South African doctors. An…

Court Strips Parents' Custody Of 4-Year-Old Son With Cancer After They Stop Chemo Treatment - David Harris Jr
Wed, 09/11/2019 - 00:02
davidharrisjr.com - Noah McAdams is a 4-year-old boy from Florida who was diagnosed with acute lymphoblastic leukemia earlier this year, and his life may hang in the balance amid an ongoing legal…
Category: Health
davidharrisjr.com - Noah McAdams is a 4-year-old boy from Florida who was diagnosed with acute lymphoblastic leukemia earlier this year, and his life may hang in the balance amid an ongoing legal…
80m Pakistanis suffering from psychological disorders: Dr Ayesha
Tue, 09/10/2019 - 22:43
thenews.com.pk - Renowned parapsychologist, hypnotherapist and spiritual healer Dr. Ayesha Ali has said that around 80 million Pakistanis are suffering from psychological, neurotic disorder and…
Category: Science
thenews.com.pk - Renowned parapsychologist, hypnotherapist and spiritual healer Dr. Ayesha Ali has said that around 80 million Pakistanis are suffering from psychological, neurotic disorder and…

Indigenous Women in Canada Are Still Being Sterilized Without Their Consent
Tue, 09/10/2019 - 22:31
vice.com - Content Warning: This story contains sensitive details about reproductive violence. S.A.T.* wanted her daughter in the room. It was the second time she'd ever spoken about her experience…
Category: Health
vice.com - Content Warning: This story contains sensitive details about reproductive violence. S.A.T.* wanted her daughter in the room. It was the second time she'd ever spoken about her experience…


Changes in Opioid-Involved Overdose Deaths by Opioid Type and...
Tue, 09/10/2019 - 20:55
cdc.gov - From 2013 to 2017, the number of opioid-involved overdose deaths (opioid deaths) in the United States increased 90%, from 25,052 to 47,600.* This increase was primarily driven by…
Category: Science
cdc.gov - From 2013 to 2017, the number of opioid-involved overdose deaths (opioid deaths) in the United States increased 90%, from 25,052 to 47,600.* This increase was primarily driven by…

Nurse: I Witnessed the Infanticide Ralph Northam Defended
Tue, 09/10/2019 - 18:13
pjmedia.com - On Tuesday, nurse Jill Stanek described her experience in caring for a baby who survived an attempted abortion. Doctors in that case followed exactly the kind of infanticide practice…
Category: Health
pjmedia.com - On Tuesday, nurse Jill Stanek described her experience in caring for a baby who survived an attempted abortion. Doctors in that case followed exactly the kind of infanticide practice…
Bacteria developing new ways to resist antibiotics, doctors warn
Tue, 09/10/2019 - 18:02
theguardian.com - Bacteria are increasingly developing ways of resisting antibiotics, threatening a future in which patients could become untreatable, doctors have warned. Over the last decade…
Category: Science
theguardian.com - Bacteria are increasingly developing ways of resisting antibiotics, threatening a future in which patients could become untreatable, doctors have warned. Over the last decade…

Missourians with disabilities winning back benefits at much lower rates, attorneys say
Tue, 09/10/2019 - 16:59
kansascity.com - On Monday, Legal Aid of Western Missouri learned that one of its clients — a woman who has suffered from a seizure disorder for 15 years — could keep the Medicaid disability benefits…
Category: Art & Entertainment
kansascity.com - On Monday, Legal Aid of Western Missouri learned that one of its clients — a woman who has suffered from a seizure disorder for 15 years — could keep the Medicaid disability benefits…
